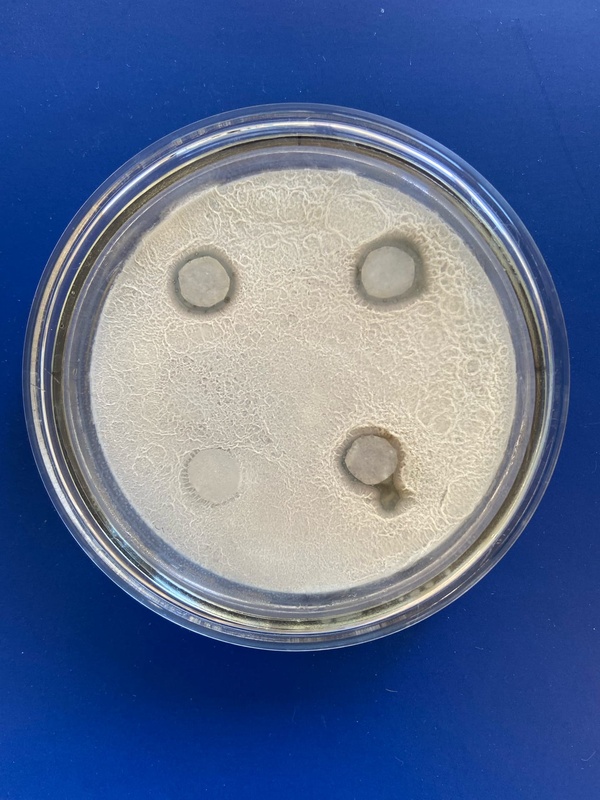
В Пермском Политехе установили антибиотические свойства молочнокислых бактерий козьего молока

В Пермском Политехе установили антибиотические свойства молочнокислых бактерий козьего молока.
Коза — животное, чье молоко превосходит коровье по многим компонентам. Оно существенно отличается по составу общим содержанием жира, витаминов, микроэлементов и лактозы. Козье молоко особенно полезно для детей. О том, что данное молоко содержит молочнокислые микроорганизмы, известно давно. Однако выделение конкретных штаммов, обладающих высокой активностью и оптимальными физиолого-биохимическими свойствами, — актуальная задача на сегодняшний день. Исследователи Пермского Политеха выделили чистую культуру молочнокислых бактерий и с использованием диско-диффузионного метода установили ее антибиотические свойства. Исследование опубликовано в сборнике «Химия. Экология. Урбанистика. 2022».
Молочнокислые бактерии — микроорганизмы, способные помимо молочной кислоты синтезировать вещества белковой природы — бактериоцины. Бактериоцины и молочная кислота оказывают ингибирующее действие на условно-патогенные и патогенные микроорганизмы, что может вызывать оздоравливающий эффект.
"Для исследования антибиотической активности применяли диско-диффузионный метод. В качестве тестируемых образцов были выбраны следующие культуры: Escherichia coli и Bacillus subtilis. В стерильные чашки Петри с агаризованной питательной средой вносили 100 микролитров односуточных культур тест-организмов и диски, пропитанные продуктами биосинтеза выделенной молочнокислой культуры", — рассказывает студентка кафедры «Химия и биотехнология» Гулюза Ибрагимова.
"Результаты изучения динамики роста показали, что культура молочнокислых бактерий обладает антибактериальной активностью в отношении как грамотрицательных, так и грамположительных микроорганизмов рассматриваемых тест-культур", — сообщает доктор технических наук, заведующий кафедрой «Химия и биотехнология» Николай Ходяшев.
По словам авторов, дальнейшие исследования могут быть ориентированы на рассмотрение антибиотической активности по отношению к более широкому кругу тест-культур микроорганизмов.